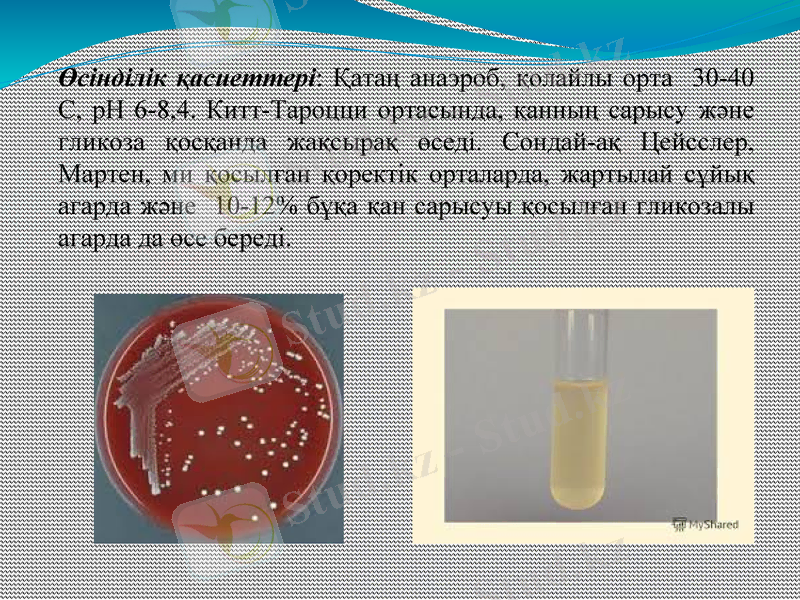
Slide 5

Сарып (Fusobacterium necrophorum): қоздырғышы, морфологиясы, эпизоотологиясы, клиникасы және емі



Некробактериоз қоздырғышы
Fusobacterium necrophorum
Орындағандар:
Тексерген:

Сарып, некробактериоз (Necrobakterіosіs), ветеринарияда - үй және жабайы жануарлар мен құстардың жұқпалы ауруы. Қоздырушысы Fusobacterіum necrophorum бактериясы. Табиғи жағдайда ауру бір аймақты түгел қамтуы мүмкін. Бұғы, жылқы, қой, сиырда Сарып тұяқ, бақай, сирақ буындарын, шошқа, бұзау, құстарда ауыз қуыстарын зақымдайды. Мүйізді ірі қара малдың жыныс мүшелерін де қамтуы ықтимал. Сарып болған малдың терісі қызарып, темп-расы 40С-қа дейін көтеріледі. Сарып асқынғанда тері астына сасық ірің жиналады, тұяғы түседі, сирақтың сіңірі зақымданады. Сарып бактериясы ауырған малдың ішек-қарын жолдарына өтіп, нәжіспен сыртқа шығады да сау малға (лас қора, жайылым, суат арқылы) жұғады. Зақымданған теріге және кілегей қабатына бактерия түссе, алғашында теріні зақымдап, кейіннен ішкі ағзаларын (бауыр, бүйрек, өкпе, жүрек, ми) жарақаттайды. Аурудың тез таралып, дамуына малды еденсіз қораларда ұстау, дымқыл жайылымға жаю, қансорғыштардың жаппай ұшып өтуі септігін тигізеді.


Морфологиясы: Грам теріс, көп пішінді таяқша, түйірлі кокко бактериялар тәрізді микроорганизм. Спора, капсула түзбейді, қозғалмайды. Ұзындығы 1, 5-3, 0 мкм, көбінесе 30-дан 400 мкм-ге дейін жіпшелер түзетін, ені 0, 5-1, 5 мкм жіңішке таяқшалар. Жіпшелері кейді шадасып жатады.
Өсінділік қасиеттері: Қатаң анаэроб, қолайлы орта 30-40 С, рН 6-8, 4. Китт-Тароцци ортасында, қанның сарысу және гликоза қосқанда жақсырақ өседі. Сондай-ақ Цейсслер, Мартен, ми қосылған қоректік орталарда, жартылай сұйық агарда және 10-12% бұқа қан сарысуы қосылған гликозалы агарда да өсе береді.

Биохимиялық қасиеті: желатинаны сұйылтпайды. Индол, күкіртті сутегін түзбейді, декстрозаны, мальтозаны, сахарозаны, салицинді ыдыратпайды, қан ыдырататын дарығыштығы жоқ, протеин ерітетін қасиеттері әлсіз байқалады.
Төзімділігі: әлсіз 65 С дейін қыздырғанда 15 минутта өледі, қайнатқан соң сол сәтте қырылады. Креолин, карбол қышқылы және формалин ерітінділері оны 20 минутта қырады. Қида 50 тәулік, ал несепте 15 тәулік сақталады.

Патогендігі және жұғу жолдары: Некробактериозбен табиғи жағдайда жануарлардың көптеген түрлері: жылқы, мүйізді ірі қара мал, марал, қой, ешкі, шошқа, мысық сонымен қатар жабай аңдар: суыр борсық, зебра, арқар ауырады.
Қоздырушысы сау жануарлардың ішегінде мекендейді, сондықтан ауру барлық жерде кездеседі. Қимен бірге бөліне отырып микроб қоршаған ортаны ластайды. Дегенмен инфекцияның негізгі жұқтырушы көзі ауру жануарлар. Заралану зақымдалған тері немесе кілегей қабық арқылы жарақаттық инфекция сипатында жүзеге асады.
Қойларды ылғалды, қиы тазаланбаған қора жайларда немесе ылғалды, батпақты жайылымдарда ұстап бағу аяқтарының төменгі бөлігіндегі тері жабына мен тұяқ мүйізінің жұмсарып, балбырауына, нәтижесінде оңай жарақаттанып, қоздырушының денеге енуіне жол ашады. Сондай ақ жайылымдағы тікенді шөптермен де терінің, әсіресе тұяқ арасындағы қуыстың жарақаттануы зарарлануға әкеп соғады. Сарыппен барлық жастағы малдар ауырады, дегенмен төлдер мен одан сәл ересектері жиі шалдығады.

Клиникалық белгілері: Бұзауларда сарып некротикалық стоматит деп аталытын ауыз қуысының зақымдалуымен сипатталатын ауру түрінде өтеді. Ауру жітілеу түрде өтеді. Азықтандырылуы, күтімі және емі жақсы болған жағдайда көбінесе жазылып кетеді, жазылу уақыты әдетте 2-3 аптаға созылады. Керісінше күтімі мен азықтандырулуы нашар болса, емдеу шаралары жүргізілмесе бұзаулар 7-10 күнде, кейде одан да ұзақ уақыттан кейін өледі.

Қойда сарып созылмалы түрде өтеді. Ауру апталарға, айларға созылуы мүмкін. Ауру кесірінен ақсай бастаған мал мейлінше жайылудан қалады. Оның үстіне организм қоздырушы уларынан улана бастайды. Некроз теріден біртіндеп тереңде жатқан ұлпаларға, сіңірлерге, байламдарға, тіпті сүйекке дейін өтеді. Бұл кезде тұяқтарының арасындағы қуыс, тұяқ жұлығы, май өкшесі күрт домбығып, ірің ағып тұратын қуыстар (іріңді фистула) пайда болады. Қой аяққа тұрудан қалады. Іріңді өліеттену құбылысы тұяқтың мүйізді қабығы астындағы теріге қарап тұяғы түсіп қалады. Оған қоса сепсис және ішкі ағзаларға қоздырушының метастазы дамиды. Осылардың барлығы, әсіресе сепсис безгекке күйзелуге, азықтан мүлде бас тартуға әкеп соқтырады. Ересек қойларда аяқтарынан басқа кейде еріндерінің терісі мен кілегейлі қабығы зақымдалады.


- Іс жүргізу
- Автоматтандыру, Техника
- Алғашқы әскери дайындық
- Астрономия
- Ауыл шаруашылығы
- Банк ісі
- Бизнесті бағалау
- Биология
- Бухгалтерлік іс
- Валеология
- Ветеринария
- География
- Геология, Геофизика, Геодезия
- Дін
- Ет, сүт, шарап өнімдері
- Жалпы тарих
- Жер кадастрі, Жылжымайтын мүлік
- Журналистика
- Информатика
- Кеден ісі
- Маркетинг
- Математика, Геометрия
- Медицина
- Мемлекеттік басқару
- Менеджмент
- Мұнай, Газ
- Мұрағат ісі
- Мәдениеттану
- ОБЖ (Основы безопасности жизнедеятельности)
- Педагогика
- Полиграфия
- Психология
- Салық
- Саясаттану
- Сақтандыру
- Сертификаттау, стандарттау
- Социология, Демография
- Спорт
- Статистика
- Тілтану, Филология
- Тарихи тұлғалар
- Тау-кен ісі
- Транспорт
- Туризм
- Физика
- Философия
- Халықаралық қатынастар
- Химия
- Экология, Қоршаған ортаны қорғау
- Экономика
- Экономикалық география
- Электротехника
- Қазақстан тарихы
- Қаржы
- Құрылыс
- Құқық, Криминалистика
- Әдебиет
- Өнер, музыка
- Өнеркәсіп, Өндіріс
Қазақ тілінде жазылған рефераттар, курстық жұмыстар, дипломдық жұмыстар бойынша біздің қор #1 болып табылады.



Ақпарат
Қосымша
Email: info@stud.kz